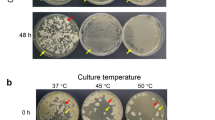

Abstract
The potential of mesophilic fermentative hydrogen-producing soil bacterium, Staphylococcus epidermidis B-6, was investigated to produce hydrogen from xylose and rice straw. This strain has the capability to utilize a variety of nitrogen and carbon sources for growth and H2 production. The better contrivance of H2 production was observed with carbon source xylose, a major fraction of lignocellulosic hydrolysate. The ambience for bio-H2 production was optimized. The maximum H2 yield was observed as 1.6 mol H2/mol xylose with a production rate of 345 mL H2/L.Day. The practical conversion of waste biomass to H2 by the strain was also investigated by batch fermentation of the acid hydrolysate of rice straw. The maximum H2 yield of 30 L/kg of rice straw was obtained from the hydrolysate prepared by treating 1% (w/v) rice straw with 0.5% (v/v) H2SO4. Thus, from this study, we found that the isolated strain Staphylococcus epidermidis B-6 is a potential candidate for fermentative H2 production and is used for the first time for the conversion of waste biomass into energy.
Access provided by Autonomous University of Puebla. Download chapter PDF
Similar content being viewed by others
Keywords
1 Introduction
Air pollution, exhaustion of fossil fuel reservoir and global warming have led to the relentless investigation for sustainable alternative fuels (Nagarajan et al. 2017). So, the production and use of non-carbonaceous fuels are getting much more attention nowadays. To elaborate, bio-based energy is a tenable and propitious replacement for unsustainable sources of energy; this can substitute and fortify against a catastrophe in the energy supply and the ever-increasing demand. Lately, hydrogen (H2) gas has gained worldwide heed and is a promising future fuel (Anwar et al. 2019; Kumar et al. 2019b). H2 is a conceivable multifaceted energy currency that could convert the utilization of non-renewable fossil fuels due to its an elevated yield per unit mass of energy (~122 kJ/g), which is 2.75 times substantial than the yield from hydrocarbon fuels (Mohan and Pandey 2019). Furthermore, upon ignition H2 produces water (H2O) after combining with O2, the only externality of the process. It is an evidently commendatory denouement for greenhouse gases (GHG) emissions. Discretely, H2 is more alike electrical energy and hence, an eminent solution (Onaran and Argun 2019). Currently, molecular H2 is fundamentally generated from fossil fuels via the process of steam reforming of methane (CH4) and/or natural gas. The global produce of H2 presently surpasses at the rate of 1 billion m3 per day, out of which around 48% is manufactured from 30% from oil, natural gas, 18% from coal and rest 4% is generated from splitting water through electrolysis (vikaspedia). When amalgamated with the steam reforming process, refined H2 is produced attained via water gas shift reaction process, a crucial industrial process utilized peculiarly for manufacturing ammonia (Singh et al. 2019). There are many more thermochemical procedures/techniques obtainable for the manufacturing of H2 that comprise autothermal reforming, catalytic oxidation, thermal decomposition, pyrolysis and steam gasification, etc. (Devasahayam and Strezov 2018; Bu et al. 2019; Waheed et al. 2016; Kouhi and Shams 2019). Nonetheless, the generation of H2 established on natural fossil fuel reservoirs augment the discharge of harmful GHGs. In this context, biologically produced hydrogen which is a carbon-neutral, sustainable and eco-friendly technique is contemplated as the most propitious candidate. It possesses high energy, is clean in nature and can be obtained from a broad range of inexhaustible feedstock (Kotay and Das 2008; Winter 2009; Chong et al. 2009).
Considering the aspect of biomass conversion to energy, dark fermentative method of H2 generation has been delineated to have huge prospective and more economic over other physicochemical methods (Bundhoo 2019). Lignocellulosic waste biomasses are promising raw materials for biofuel production due to high carbohydrate percentage (Taherzadeh and Karimi 2008; Nissilä et al. 2014). However, the sugar polymer cellulose and hemicelluloses in lignocellulosic biomass remain bound in compact form with lignin, which restrict them from easy microbial degradation. A few fungi are capable of solubilizing lignin, and some bacterial species can degrade cellulose, but the process takes a very long time (Lee 1997; Lynd et al. 2002; Kumar et al. 2008, Kumar et al. 2019a). Thus, these substances require proper pre-treatment prior to fermentative hydrogen production. Xylose shares a major fraction (35–45%) of total sugar yield from hydrolysis of lignocellulosic materials (Lavarack et al. 2002). Extensive research has been done on H2 production via fermentation from substrates such as glucose and sucrose. However, due to inefficiency of microbes for xylose utilization, there are a very few reports (Li et al. 2010; Cheng et al. 2012; Chenxi et al. 2013; Wu et al. 2014; An et al. 2014; Poladyan et al. 2018; López-Aguado et al. 2018; Zhao et al. 2019; Kongjan et al. 2019) on H2 production from xylose using a pure culture of microbes. Hence, for complete utilization of sugar released from lignocellulosic material, it is important to isolate bacterial species with efficiency to convert xylose to H2. Thus, our current work is based on the isolation and identification of new microbial (bacteria) species having the potential to utilize xylose for fermentative H2 production. Parameters that are crucial for fermentation was also studied to ascertain the optimum parameters for maximal H2 yield and high production rate. This study also investigates the feasibility of the isolated bacterium for H2 production from acid hydrolysed rice straw under batch culture condition.
2 Materials and Methods
2.1 Isolation of H2-Producing Bacteria
The bacterial strain for H2 production was isolated from the soil sample collected from the outskirt of Kaziranga national park of North East India. For isolation of bacterial strain, 1 g of the soil sample was homogenized with 0.85% NaCl (w/v) followed by several-fold dilution. 100 uL of the diluted sample was then spread on nutrient agar plates and kept at 37 °C for 24 h. Several bacterial colonies differing by colony morphology were obtained and were subsequently maintained as a pure culture for screening of H2 production ability from xylose.
2.2 Screening for H2 Production from Xylose and Culture Condition
The preliminary screening of bacterial strains for H2 production from xylose was done under batch culture condition. The medium used was GM-2 (Yeast extract—1.0 g/L, K2HPO4 —1.0 g/L, MgSO4.7H2O—0.5 g/L and FeSO4.7H2O—1 mg/L) with slight modification (Patel et al. 2014). The experiments were conducted in 125 mL BOD bottle under anaerobic condition. 100 mL of the medium supplemented with 5 g/L xylose was inoculated with 2% (v/v) of culture (1 O.D at 600 nm). After bacterial inoculation, the bottles were made airtight and initial anaerobic condition was established by flushing N2 gas. The bottles were then kept at 37 °C and evolved biogas was collected by water displacement method under acidic water. The potential strain with maximum biogas production ability was selected for this study and was named as strain B-6.
2.3 Identification of the Bacterial Strain B-6
For identification of the bacterial strain B-6, 16S rRNA gene sequencing was done by using universal primers, 27F (5ʹAGAGTTTGATCCTGGCTCAG3ʹ) and 1492R (5ʹGGTTACCTTGTTACGACTT3ʹ). The amplified product was purified by using PCR purification kit (Qiagen) and sent for sequencing (Eurofins Genomics India Pvt. Ltd., India). The obtained sequence was subjected to BLAST in National Centre of Biotechnology information (NCBI) BLAST search tool and the phylogenetic tree was constructed using the neighbour-joining method with MEGA 5.2 software.
2.4 Optimization of Culture Condition
The parameters crucial for fermentative H2 production including initial pH, nitrogen source and substrate concentration were optimized under batch culture condition. The effect of pH was studied by adjusting the initial pH of the fermentation medium with the pH range of 5–9 with incremental step of 1. The fermentation was carried out at 37 °C with xylose concentration 10 g/L. The effect of nitrogen source on H2 production was studied by fermentation medium GM-2 amended with inorganic (ammonium sulphate, ammonium chloride) and organic (yeast extract, peptone) nitrogen sources at a concentration of 1.0 g/L. The initial pH was 7.0, fermentation temperature 37 °C and xylose concentration 10 g/L. The effect of xylose concentration on fermentation was studied by varying the initial xylose load from 5–50 g/L under optimum pH, and nitrogen source at 37 °C.
2.5 H2 Production with Different Carbon Source
The ability of the selected strain for utilization of other carbon sources were studied at optimum conditions (pH–7, N2 source–yeast extract and incubation temperature –37 °C). The different carbon sources used were glucose, fructose, sucrose, mannose, lactose (10 g/L) and glycerol (10 mL/L).
2.6 Acid Hydrolysis of Rice Straw
Acid hydrolysis of the hemicellulose fraction of the rice straw was conducted by treating the dry rice straw (1%, 2%, 3%, 5% and 7%, w/v) with diluted H2SO4 (0.5%, v/v) at 121 °C for one hour in autoclave. After hydrolysis, the hydrolysate was filtered through a thin cloth to remove the solid fraction. Over-liming of the hydrolysate was done by adding Ca(OH)2 with frequent stirring and the final pH adjusted to 10. The resulting precipitate was removed by centrifugation at 1500 rpm for 15 min. The supernatant was then re-acidified by lowering the pH to 7 and again centrifuged. The final supernatant thus obtained was then used for fermentative H2 production (Nigam 2000).
2.7 Analytical Methods
The amount of biogas evolved during fermentation was measured by the water displacement method. The gas components were analysed by gas chromatograph (Nucon GC5765, India) equipped with Porapak-Q and molecular sieve columns using a thermal conductivity detector (Nath et al. 2015). Argon was used as carrier gas with a flow rate of 20 mL/min, and temperature of oven, injector and detector was set to 60, 80 and 110 °C, respectively. The xylose concentration was measured by DNS method (Miller 1959).
3 Results and Discussion
3.1 Strain Identification and Phylogenetic Analysis
The sequenced 16S rRNA gene of the strain B-6 was aligned with gene bank NCBI (http://blast.ncbi.nlm.nih.gov) using BLAST program. A phylogenetic tree was constructed by neighbour-joining method with MEGA 5.2 software (Fig. 21.1). The tree indicates that the strain B-6 belonged to the genus Staphylococcus and showed maximum similarity with Staphylococcus epidermidis strain NBRC100911. Thus, the strain was identified and named as Staphylococcus epidermidis B-6. The gene sequence was also submitted to the NCBI gene bank with an accession number KT072716.
3.2 Effect of Various Nitrogen Sources on H2 Production
The effect of various nitrogen sources on H2 production by Staphylococcus epidermidis B-6 is shown in Fig. 21.2a–c. A significant change in H2 production was observed by changing the source of nitrogen in the fermentation medium. The maximum H2 yield of 1.55 mol H2/mol xylose was observed using yeast extract with the highest bacterial growth and 98% of xylose consumption (Fig. 21.2a, b). This is due to the fact that yeast extract is a complex nitrogen source comprising of peptides and amino acids, which can be easily taken up by the bacterium during fermentation and directly incorporated into proteins or transformed into other cellular nitrogenous constituents (Large 1986; Ferchichi et al. 2005). On the other hand, when inorganic nitrogen sources are used, the cells have to spend more energy in synthesizing amino acids, and as a result, they spend a longer period of lag phase and decrease in H2 yield (An et al. 2014). The results suggest that yeast extract as a better nitrogen source for maximum H2 production with high production rate and bacterial growth. However, the other cheap nitrogen sources like ammonium chloride and ammonium sulphate also showed relatively higher production of H2 (Fig. 21.2a). Thus, this can be beneficial for industrial-scale H2 production by using cheap inorganic nitrogen sources instead of expensive organic nitrogen sources.
3.3 Effect of Initial pH on H2 Production
The effect of initial pH on H2 production by Staphylococcus epidermidis B-6 was investigated at pH 5–9 (with an interval of pH 1). The result (Fig. 21.3a–c) showed that the initial pH of the medium is an important factor in the bacterial growth and H2 production process. The yield of H2 and cell growth was increased significantly by increasing the initial pH from 5 to 7 and then decreased by further increasing the pH (Fig. 21.3b). The rate of hydrogen production (Fig. 21.3a) and xylose degradation (Fig. 21.3c) also showed a similar trend with cell growth and H2 yield as shown in Fig. 21.3b. The maximum H2 yield is 1.6 mol H2/mol xylose with hydrogen production rate of 342 mL H2/L. Day was observed at pH 7. The cell growth and xylose consumption were also observed maximum at this pH. The H2 yield and cell growth were very low at pH 5 and bellow that no growth and H2 evolution was observed. This can be the fact that, at high concentration of H+ ion environment, the cell’s ability to maintain internal pH get destabilized, consequently intracellular ATP level drops and inhibiting xylose uptake (Nigam et al. 1985; Xu et al. 2010). However, the strain B-6 was found to produce H2 above 1 mol/mol xylose within the pH range of 6–9 and very little or no gas production was observed by further increasing the pH. This can be the fact that at higher pH range, the activity of the key enzyme [Fe − Fe] hydrogenase gets decreased and the changing direction of metabolic pathway from acidogenesis to solventogenesis results into low H2 production (Zhu and Yang 2004; Gadhe et al. 2013).
3.4 Effect of Initial Xylose Concentration on H2 Production
The initial substrate load usually plays a crucial role in cell growth and H2 production. Figure 21.4a–c shows the various effects of initial xylose concentration on fermentation. An increase in the H2 yield from 1.4 to 1.6 mol H2/mol xylose was observed by increasing the xylose concentration from 5 to 10 g/L and was then decreased by further increasing the concentration. Though the volume of H2 production (Fig. 21.4a) was relatively higher by increasing xylose concentration above 10 g/L, but the rate of production was found gradually decreases with H2 yield and xylose consumption rate (Fig. 21.4b, c). However, cell growth was observed maximum at 20 g/L xylose concentrations and was then decreased above this concentration. This is due to the fact that at higher substrate concentration, the yield is decreased by inhibitory effect of substrates (Lin and Cheng 2006). Another reason may be that at higher substrate concentration, the carbon flux is directed more towards the production of reduced by-products like organic acids and alcohols (Chittibabu et al. 2006). The undissociated organic acids get accumulated in the fermentation broth with higher substrate concentration, which would leak into the cell and decrease the pH of the intracellular environment. As a consequence, the cell growth and H2 yield get inhibited (Akutsu et al. 2009).
3.5 Utilization of Different Carbon Sources
It is important for H2 producing bacterial strain to have the ability to use various carbon sources for better utilization of complex waste biomass. A variety of carbon sources have been reported for fermentative H2 production. Therefore, different carbon sources were fed to evaluate their effect on H2 production by Staphylococcus epidermidis B-6. The hydrogen production data (Fig. 21.5) showed that the bacterium can utilize diverse carbon sources. H2 production was observed with lactose (305 mL H2/g), maltose (280 mL H2/g), xylose (240 mL H2/g), fructose (180 mL H2/g), glycerol (120 mL H2/g) and glucose (70 mL H2/g). Thus, the ability of the strain B-6 to utilize a wide variety of carbon sources for H2 production would be of great impact on waste management and converting the waste biomass to energy (Kapdan and Kargi 2006; Chong et al. 2009).
3.6 Production of H2 from Rice Straw Hydrolysate
The lignocellulosic hydrolysate obtained from wood, agricultural waste by-product and crop contains a major fraction of xylose (Lavarack et al. 2002). As the strain Staphylococcus epidermidis B-6 was found potential in utilizing xylose for H2 production, thus its feasibility to produce H2 from acid hydrolysate of rice straw was examined. For this, the different concentration of dried rice straw was treated with diluted H2SO4 and the hydrolysate was used for batch fermentation. The maximum H2 yield of 30 L/kg rice straw was observed with hydrolysate prepared by treating 1% (w/v) rice straw and the yield was decreased by further increasing the rice straw concentration (Fig. 21.6). Diluted acid was used for the hydrolysis process (0.5% v/v). Increasing the acid concentration in acid hydrolysis could provide a strong or complete reaction for hydrolysis, yielding more hydrolysed product (Chong et al. 2004). However, at higher acid concentration, the conversion of sugars to various inhibitory compounds takes place, which retard the cell growth. Furfural is one such compound, which is generated as a degradation product from xylose at higher H2SO4 concentration (Aguilar et al. 2002). The results suggest that the strain can be used for large scale H2 production and can help on the way of complete utilization of lignocellulosic waste hydrolysate. This will be a great benefit for the conversion of waste into energy and reduce the waste generation (Fig. 21.7; Table 21.1).
4 Conclusions
Biohydrogen production by dark fermentative microbes is a sustainable solution to manage lignocellulosic wastes which are hard to solubilize. Staphylococcus epidermidis B-6 was used for the first time to produce bio-H2 from xylose and rice straw. The highest H2 yield obtained was 1.6 mol H2/mol and 30 L/kg from xylose and rice straw respectively. The results suggested that the strain could be used for complete utilization of lignocellulosic waste hydrolysate and production of H2 on a large scale. This will be a great benefit for the conversion of waste into energy and provide an economic technology to manage generated waste.
References
Aguilar R, Ramírez JA, Garrote G, Vázquez M (2002) Kinetic study of the acid hydrolysis of sugarcane bagasse. J Food Eng 55:309–318
Akutsu Y, Li YY, Harada H, Yu HQ (2009) Effect of temperature and substrate concentration on biological hydrogen production from starch. Int J Hydrogen Energy 34:2558–2566
An D, Li Q, Wang X, Yang H, Guo L (2014) Characterization on hydrogen production performance of a newly isolated Clostridium beijerinckii YA001 using xylose. Int J Hydrogen Energy 39:19928–19936
Anwar M, Lou S, Chen L, Li H, Hu Z (2019) Recent advancement and strategy on bio-hydrogen production from photosynthetic microalgae. Bioresour Technol. https://doi.org/10.1016/j.biortech.2019.121972
Bu E, Chen Y, Wang C, Cheng Z, Luo X, Shu R, Zhang J, Liao M, Jiang Z, Song Q (2019) Hydrogen production from bio-derived biphasic photoreforming over a raspberry-like amphiphilic Ag2O-TiO2/SiO2 catalyst. Chem Eng J 370:646–657
Bundhoo ZMA (2019) Potential of bio-hydrogen production from dark fermentation of crop residues: a review. Int J Hydrogen Energy 44:17346–17362
Cao G, Ren N, Wang A, Lee DJ, Guo W, Liu B (2009) Acid hydrolysis of corn stover for biohydrogen production using Thermoanaerobacterium thermosaccharolyticum W16. Int J Hydrogen Energy 34:7182–7188. https://doi.org/10.1016/j.ijhydene.2009.07.009
Cheng J, Song W, Xia A, Su H, Zhou J, Cen K (2012) Sequential generation of hydrogen and methane from xylose by two-stage anaerobic fermentation. Int J Hydrogen Energy 37:13323–13329
Cheng J, Lin R, Ding L, Song W, Li Y, Zhou J (2015) Fermentative hydrogen and methane cogeneration from cassava residues: effect of pre-treatment on structural characterization and fermentation performance. Bioresour Technol 179:407–413. https://doi.org/10.1016/j.biortech.2014.12.050
Chenxi Z, Wenjing L, Hongtao W, Xiangliang P (2013) Simultaneous hydrogen and ethanol production from a mixture of glucose and xylose using extreme thermophiles I: effect of substrate and pH. Int J Hydrogen Energy 38:9701–9706
Chittibabu G, Nath K, Das D (2006) Feasibility studies on the fermentative hydrogen production by recombinant Escherichia coli BL-21. Process Biochem 41:682–688
Chong AR, Ramírez JA, Garrote G, Vázquez M (2004) Hydrolysis of sugarcane bagasse using nitric acid: a kinetic assessment. J Food Eng 61:143–152
Chong ML, Sabaratnam V, Shirai Y, Hassan MA (2009) Biohydrogen production from biomass and industrial wastes by dark fermentation. Int J Hydrogen Energy 34:3277–3287
Chong PS, Jahim JM, Harun S, Lim SS, Mutalib SA, Hassan O (2013) Enhancement of batch biohydrogen production from prehydrolysate of acid treated oil palm empty fruit bunch. Int J Hydrogen Energy 38, 9592–9599. https://doi.org/10.1016/j.ijhydene.2013.01.154
Devasahayam S, Strezov V (2018) Thermal decomposition of magnesium carbonate with biomass andplastic wastes for simultaneous production of hydrogen and carbonavoidance. J Clean Prod 174:1089–1095
Ferchichi M, Crabbe E, Hintz W, Gil GH, Almadidy A (2005) Influence of culture parameters on biological hydrogen production by Clostridium saccharoperbutylacetonicum ATCC 27021. World J Microbiol Biotechnol 21:855–862
Gadhe A, Sonawane SS, Varma MN (2013) Optimization of conditions for hydrogen production from complex dairy wastewater by anaerobic sludge using desirability function approach. Int J Hydrogen Energy 38:6607–6617
Gonzales RR, Kim SH (2017) Dark fermentative hydrogen production following the sequential dilute acid pretreatment and enzymatic saccharification of rice husk. Int J Hydrogen Energy 42:27577–27583
Kongjan P, Inchan, S, Chanthong S, Jariyaboon R, Reungsang A, O-Thong S (2019) Hydrogen production from xylose by moderate thermophilic mixed cultures using granules and biofilm up-flow anaerobic reactors. Int J Hydrogen Energy 44, 3317–3324
Kaparaju P, Serrano M, Thomsen AB, Kongjan P, Angelidaki I (2009) Bioethanol, biohydrogen and biogas production from wheat straw in a biorefinery concept. Bioresour Technol 100:2562–2568. https://doi.org/10.1016/j.biortech.2008.11.011
Kapdan KI, Kargi F (2006) Bio-hydrogen production from waste materials. Enzyme Microb Technol 38:569–582
Kotay SM, Das D (2008) Biohydrogen as a renewable energy resource-prospects and potentials. Int J Hydrogen Energy 33:258–263
Kouhi M, Shams K (2019) Bulk features of catalytic co-pyrolysis of sugarcane bagasse and ahydrogen-rich waste: the case of waste heavy paraffin. Renew Energy 140:970–982
Kumar R, Singh S, Singh OV (2008) Bioconversion of lignocellulosic biomass: biochemical and molecular perspectives. J Ind Microbiol Biotechnol 35:377–391
Kumar M, Ram B, Honda R, Poopipattana C, Canh VD, Chaminda T, Furumai H (2019a) Concurrence of antibiotic resistant bacteria (ARB), viruses, pharmaceuticals and personal care products (PPCPs) in ambient waters of Guwahati, India: urban vulnerability and resilience perspective. Sci Total Environ 693:133640. https://doi.org/10.1016/j.scitotenv.2019.133640
Kumar M, Chaminda T, Honda R, Furumai H (2019c) Vulnerability of urban waters to emerging contaminants in India and Sri Lanka: resilience framework and strategy. APN Sci Bull 9(1). https://doi:10.30852/sb.2019.799
Kumari S, Das D (2016) Biologically pretreated sugarcane top as a potential raw material for the enhancement of gaseous energy recovery by two stage biohythane process. Bioresour Technol 218:1090–1097. https://doi.org/10.1016/j.biortech.2016.07.070
Large PJ (1986) Degradation of organic nitrogen compounds by yeasts. Yeast 2:1–34
Lavarack BP, Griffin GJ, Rodman D (2002) The acid hydrolysis of sugarcane bagasse hemicellulose to produce xylose, arabinose, glucose and other products. Biomass Bioenergy 23:367–380
Lee J (1997) Biological conversion of lignocellulosic biomass to ethanol. J Biotechnol 56:1–24
Li S, Lai C, Cai Y, Yang X, Yang S, Zhu M, Wang J, Wang X (2010) High efficiency hydrogen production from glucose/xylose by the ldh-deleted thermoanaerobacterium strain. Biores Technol 101:8718–8724
Li Y, Zhang Z, Zhu S, Zhang H, Zhang Y, Zhang T, Zhang Q (2018) Comparison of bio-hydrogen production yield capacity betweenasynchronous and simultaneous saccharification and fermentation processesfrom agricultural residue by mixed anaerobic cultures. Biores Technol 247:1210–1214
Lin CY, Cheng CH (2006) Fermentative hydrogen production from xylose using anaerobic mixed microflora. Int J Hydrogen Energy 31:832–840
Lo YC, Lu WC, Chen CY, Chang JS (2010) Dark fermentative hydrogen production from enzymatic hydrolysate of xylan and pretreated rice straw by Clostridium butyricum CGS5. Bioresour. Technol 101, 5885–5891. https://doi.org/10.1016/j.biortech.2010.02.085
López-Aguado C, Paniagua M, Iglesias J, Morales G, García-Fierro JL, Melero JA (2018) Zr-USY zeolite: efficient catalyst for the transformation of xylose into bioproducts. Catal Today 304:80–88
Lynd LR, Weimer PJ, Van ZWH, Pretorius IS (2002) Microbial cellulose utilization: fundamentals and biotechnology. Microbiol Mol Biol Rev 66:506–577
Miller GL (1959) Use of dinitrosalicylic acid reagent for determination of reducing sugar. Anal Chem 31:426–428
Mohan SV, Pandey A (2019) Chapter 1—Sustainable hydrogen production: an introduction. Biomass, Biofuels, Biochemicals, Biohydrogen (second edition) 1-23
Nagarajan D, Lee DJ, Kondo A, Chang JS (2017) Recent insights into biohydrogen production by microalgae–From biophotolysis to dark fermentation. Biores Technol 227:373–387
Nath D, Manhar Ak, Gupta K, Saikia D, Das SK, Mandal M (2015. Phytosynthesized iron nanoparticles: effects on fermentative hydrogen production by Enterobacter cloacae DH-89. Bull Mater Sci 38:1533–1538
Nigam JN (2000) Cultivation of Candida langeronii in sugarcane bagasse hemicellulosic hydrolysate for the production of single cell protein. World J Microbiol Biotechnol 16:367–372
Nigam JN, Margaritis A, Lachance MA (1985) Aerobic fermentation of D-xylose to ethanol by Clavispora sp. Appl Environ Microbiol 50:763–766
Nissilä ME, Lay CH, Puhakka JA (2014) Dark fermentative hydrogen production from lignocellulosic hydrolyzates -a review. Biomass Bioenergy 67:145–159
Onaran G, Argun H (2019) Direct current assisted bio-hydrogen production from acid hydrolyzed waste paper. Int J Hydrogen Energy 44:18792–18800
Patel SKS, Kumar P, Mehariya S, Purohit HJ, Lee JK, Kalia VC (2014) Enhancement in hydrogen production by co-cultures of Bacillus and Enterobacter. Int J Hydrogen Energy 39:14663–14668
Poladyan A, Baghdasaryan L, Trchounian A (2018) Escherichia coli wild type and hydrogenase mutant cells growth and hydrogen production upon xylose and glycerol co-fermentation in media with different buffer capacities. Int J Hydrogen Energy 43:15870–15879
Singh A, Patel AK, Deka JP, Das A, Kumar A, Kumar M (2019) Prediction of arsenic vulnerable zones in groundwater environment of rapidly urbanizing setup, Guwahati, India. Geochemistry 125590. https://doi.org/10.1016/j.chemer.2019.125590
Taherzadeh MJ, Karimi K (2008) Pretreatment of lignocellulosic wastes to improve ethanol and biogas production: a review. Int J Mol Sci 9:1621–1651
Waheed QMK, Wu C, Williams PT (2016) Hydrogen production from high temperature steam catalytic gasification of bio-char. J Energy Inst 89(2):222–230
Wieczorek N, Kucuker MA, Kuchta K (2014) Fermentative hydrogen and methane production from microalgal biomass (Chlorella vulgaris) in a two-stage combined process. Appl Energy 132:108–117
Winter CJ (2009) Hydrogen energy—abundant, efficient, clean: a debate over the energy-system-of-change. Int J Hydrogen Energy 34:S1–S52
Wu XB, Huang GF, Bai LP, Long MN, Chen QX (2014) Enhanced hydrogen production from xylose and bamboo stalk hydrolysate by overexpression of xylulokinase and xylose isomerase in Klebsiella oxytoca HP1. Int J Hydrogen Energy 39:221–230
Xu JF, Ren NQ, Wang AJ, Qiu J, Zhao QL, Feng YJ, Liu BF (2010) Cell growth and hydrogen production on the mixture of xylose and glucose using a novel strain of Clostridium sp. HR-1 isolated from cow dung compost. Int J Hydrogen Energy 35:13467–13474
Xu J, Upcraft T, Tang Q, Guo M, Huang Z, Zhao M, Ruan W (2019) Hydrogen generation performance from Taihu Algae and food waste by Anaerobic Codigestion. Energy Fuels 33(2):1279–1289
Yin Y, Hu J, Wang J (2019) Fermentative hydrogen production from macroalgae Laminaria japonica pretreated by microwave irradiation. Int J Hydrogen Energy 44(21):10398–10406
Zhao L, Wang ZH, Wu JT, Ren HY, Yang SS, Nan J, Cao GL, Sheng YC, Wang AJ, Ren NQ (2019) Co-fermentation of a mixture of glucose and xylose to hydrogen by Thermoanaerobacter thermosaccharolyticum W16: characteristics and kinetics. Int J Hydrogen Energy 44:9248–9255
Zhu Y, Yang ST (2004) Effect of pH on metabolic pathway shift in fermentation of xylose by Clostridium tyrobutyricum. J Biotechnol 110:143–157
Acknowledgements
This research work was financially supported by Department of Biotechnology (Ref. No. BT/212/NE/TBP/2011 dated December 14, 2011), New Delhi, India. Mr. D. Nath was the recipient of Junior Research Fellowship (File No: 09/796(0060)/2015-EMR-I) from the Council of Scientific and Industrial Research (CSIR), New Delhi. The authors also acknowledge the help extended by Tezpur University, Assam, India, by providing infrastructure and other necessary facilities to carry out the research work successfully.
Author information
Authors and Affiliations
Corresponding author
Editor information
Editors and Affiliations
Rights and permissions
Copyright information
© 2020 Springer Nature Singapore Pte Ltd.
About this chapter
Cite this chapter
Mazumder, P., Nath, D., Manhar, A.K., Gupta, K., Saikia, D., Mandal, M. (2020). Dark Fermentative Hydrogen Production from Lignocellulosic Agro-waste by a Newly Isolated Bacteria Staphylococcus Epidermidis B-6. In: Kumar, M., Munoz-Arriola, F., Furumai, H., Chaminda, T. (eds) Resilience, Response, and Risk in Water Systems . Springer Transactions in Civil and Environmental Engineering. Springer, Singapore. https://doi.org/10.1007/978-981-15-4668-6_21
Download citation
DOI: https://doi.org/10.1007/978-981-15-4668-6_21
Published:
Publisher Name: Springer, Singapore
Print ISBN: 978-981-15-4667-9
Online ISBN: 978-981-15-4668-6
eBook Packages: Earth and Environmental ScienceEarth and Environmental Science (R0)